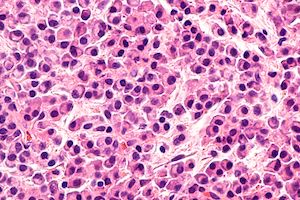
Study Examines Cost-Effectiveness in Multiple Myeloma Treatments

American workers between the ages of 49 and 57 with at least 10 paid sick days had a significant increase in receiving preventive services, such as a flu shot, checking cholesterol and blood pressure, and a fasting blood sugar test for diabetes.

American workers between the ages of 49 and 57 with at least 10 paid sick days had a significant increase in receiving preventive services, such as a flu shot, checking cholesterol and blood pressure, and a fasting blood sugar test for diabetes.

Savings hospitals had lower baseline spending than nonsavings hospitals during the first year of the Comprehensive Care for Joint Replacement (CJR) program, according to a Research Letter in JAMA.

Health equity can only be achieved when leaders and policy makers are passionate about reducing health disparities and adamantly encourage care delivery reforms that incentivize and support health equity efforts.

Patients who had breast cancer or lymphoma who were treated more than 3 times are more likely to develop congestive heart failure than those who did not have cancer, according to research being presented at the American College of Cardiology’s 67th Annual Scientific Session.

A continued shift towards value-based care incentivizes better health behaviors and improves coordination of care among healthcare providers by focusing on cost savings, according to UnitedHealthcare’s second annual report on value-based care.

During a discussion, 4 panelists addressed their main issues of growing up with rare diseases, including that physicians often doubted their feelings of pain and distress.

Mindfulness meditation is effective in treating adults with attention-deficit/ hyperactivity disorder (ADHD), according to a study published in the Journal of Attention Disorders.

More than half of physicians find that their patients encounter coverage issues due to inaccurate information included in payer directories at least once per month, according to a survey from the American Medical Association (AMA) and LexisNexis Risk Solutions.

States that implement strict laws to limit smoking in public areas and add heavy taxes on cigarettes have a lower rate of not only cigarette users, but also e-cigarette users, according to a report from NYU School of Medicine and the NYU College of Global Public Health.

In California, 1 minute of operating room (OR) time costs an average $36 to $37 per minute, according to a study published in JAMA Surgery. Hospital costs are important to understanding value-based care, and are even more critical when analyzing cost-saving interventions during surgery, the study said.

A lack of communication among older Americans and their physicians increases unnecessary healthcare spending on unneeded scans, screenings, medications, and procedures for the patient, according to a survey from the National Poll on Healthy Aging.

Commercially insured individuals with health plans with value-based contracts for diabetes, high cholesterol, and HIV medicines had average co-pays that were 28% lower for those prescription medications compared with people on other plans, according to a report from the Pharmaceutical Research and Manufacturers of America (PhRMA).

The identification of 16 items specific to patient-reported outcomes (PROs) by the SPIRIT-PRO Extension can improve the quality and use of PRO data.

Partners in Healing, a program where family members of hospitalized patients are invited to take part in caring for their loved ones, reduced readmission rates and enhanced the healing process for patients, according to a study published in CHEST.

Blood or marrow transplantation (BMT) can have an impact on a patient’s cognitive functioning, affecting a survivor’s ability to integrate with a group of people and return to work. In addition, BMT recipients can experience a weakened memory, a loss of attention and concentration, and difficulty learning.

Policy changes are needed to increase risk-adjustment payments for special enrollment period (SEP) enrollees. A new study in Health Affairs, the current payment-adequacy difference between full-year members and SEP enrollees has a high probability of increasing.

A working paper published by the National Bureau of Economic Research identified an association between employees who choose to participate in firm-sponsored wellness programs and lower average healthcare spending and healthy habits, like clean eating and exercise. However, employees who participate already practice heathy lifestyles and have low spending.

Integrating nonmedical social services with medical services is necessary for the United States healthcare system to address unmet social needs, according to a case study published in Health Affairs.

In Kentucky, Medicaid enrollees now facing a work requirement will experience barriers that limit their ability to reach the requisite 80 hours’ worth of “community engagement” activities or document exemptions including low educational attainment, health limitations, and a lack of access to a vehicle and the internet.

Adults with serious mental illnesses are at high risk of developing chronic diseases, resulting in shortened lifespans. Patient self-directed and provider-supported approaches significantly increase patient activation in care, engagement in primary and specialty care, and perceived mental health status among patients with serious mental health issues, according to new research.

Cancer survivors may be able to manage the extreme fatigue they experience after treatment by knowingly taking a placebo pill, according to researchers at University of Alabama at Birmingham and Harvard Medical School.

Among high-, middle-, and low-income countries, more than 1 in 10 patients who had gastrointestinal surgeries worldwide resulted in a surgical site infection within 30 days of the operation, according to a study published in The Lancet Infectious Diseases.

Merkel cell carcinoma (MCC) is a rare disease, but it's getting less rare. Study results presented at the American Academy of Dermatology 2018 Annual Meeting found that cases of MCC increased 95% between 2000 and 2013

Value-based care and interoperability continue to progress in the United States, but barriers that limit sharing of clinical information among hospitals, physicians, and health plans remain, according to a study by the Healthcare Financial Management Association (HFMA) and sponsored by Humana.

Language in the new government budget ensures effective changes to CMS' Competitive Bidding Program for diabetes testing supplies that will benefit patients with diabetes.

In the United States, health varies among communities and regions. People living in urban areas have different health issues than those living in rural areas based on cultures that either promote healthy lifestyles or limit access to healthcare.

An individual’s body mass index (BMI) can increase when exposed to counties with a higher prevalence of obesity, according to a study published in JAMA Pediatrics.

Native Americans experience a variety of health determinants in their everyday lives, and agencies like the Alaska Native Tribal Health Consortium and the Indian Health Service, along with insurance company Premera Blue Cross, have prioritized American Indian and Alaska Native health.

Black patients with prostate cancer are underrepresented in clinical trials due to eligibility requirements that exclude patients with benign ethnic neutropenia, according to a new study published in JAMA Oncology.

Patients with metastatic urothelial cancer treated with atezolizumab monotherapy demonstrated tolerability for the drug and general ability to manage adverse effects, according to a study published in JAMA Oncology.

Published: January 3rd 2018 | Updated:

Published: January 4th 2018 | Updated:

Published: January 5th 2018 | Updated:
Published: January 6th 2018 | Updated:

Published: January 10th 2018 | Updated:

Published: January 10th 2018 | Updated:

259 Prospect Plains Rd, Bldg H
Cranbury, NJ 08512
© 2025 MJH Life Sciences®
All rights reserved.
